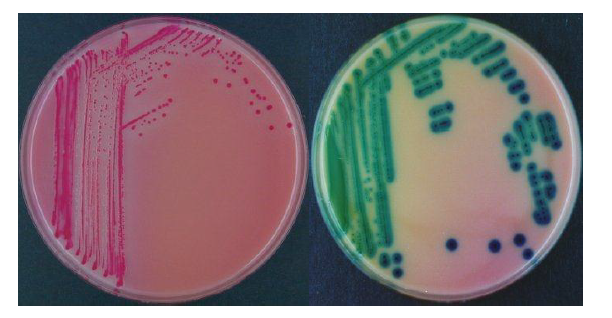

Хромогенные среды для обнаружения сальмонелл: как они работают

:strip_icc():format(jpeg)/kly-media-production/medias/32124/original/salmonella-130820b.jpg)










Раздел: Образы и смыслы